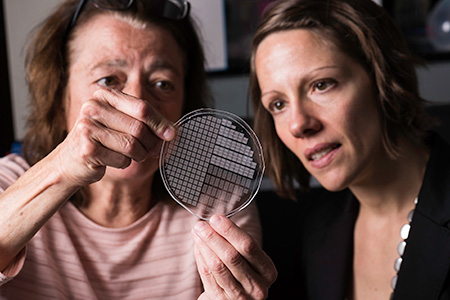

Turning the Tap Back On
NIDCR-supported research aims to repair damaged salivary glands and restore saliva flow
Saliva might just be the unsung hero of our everyday life. It lubricates our mouths, keeps our teeth and gums healthy, helps break down food, and protects us from harmful germs. So, when saliva dwindles, it can spell trouble.
Globally, about one in five people experience dry mouth due to a breakdown in saliva production. Without enough saliva, chewing, swallowing, and even talking can be difficult. It may also cause burning sensations in the mouth, hard-to-heal oral ulcers, and an increased risk of tooth decay and infections.
Salivary dysfunction can be caused by genetic diseases, certain medications, and autoimmune disorders such as Sjögren’s disease, where immune cells mistakenly attack healthy cells in the salivary and tear glands. Radiation therapy for head and neck cancer can also damage glands and hamper saliva production.
While clinicians can prescribe drugs to boost saliva flow, the side effects — profuse sweating, gastrointestinal problems, and irregular heartbeat — have steered many patients away from their use. In some cases, the glands are too damaged to respond to drugs, highlighting the need for better solutions.
For decades, NIDCR-supported scientists have investigated the underlying causes of salivary gland dysfunction and explored emerging technologies for new therapies. This work includes efforts to identify the genetic and molecular underpinnings of Sjögren’s disease, regenerate diseased salivary gland tissue, and use cell-loaded tissue chips to test radioprotective drugs. Since the early 1990s, NIDCR scientists have also been exploring gene therapy to restore salivary gland function, launching the first clinical trial to treat radiation-damaged salivary glands in 2008.
“It’s easy to take our saliva for granted. The reality is salivary gland dysfunction diminishes quality of life and represents an unmet clinical need for millions of people in the United States,” said NIDCR Director Rena D’Souza, D.D.S., Ph.D. “Over the past few decades, the institute has made great strides — from uncovering the fundamentals of salivary gland biology to testing promising experimental therapies in human clinical trials.”
Tapping into gene therapy
Salivary glands are small organs with a big job. Humans have three pairs of major salivary glands that range from about the size of a kidney bean to a small egg. Located under the tongue, ears, and jaw, they collectively churn out a liter of saliva a day. Acinar cells in the glands pull fluid from the blood through molecular water channels embedded in the cell membranes. Once fluid is inside a gland, it’s mixed with proteins, digestive enzymes, and other compounds and excreted into the mouth as saliva. However, radiation can damage or kill acinar cells and disrupt the glands’ ability to draw in water, leaving the mouth dry.
In the early 1990s, institute scientists landed on the idea of using a non-infectious virus to deliver genetic instructions to the remaining gland tissue to make more water channels, thus restoring saliva flow. The researchers, led by Bruce Baum, Ph.D., and James Turner, Ph.D., spent the next decade-and-a-half developing and testing the concept. John Chiorini, Ph.D., a virology expert, was brought on in 1998 to optimize the viral delivery vehicle. The team eventually showed that the gene therapy worked to restore saliva flow in the radiation-damaged glands of animals.
The idea was put to the test in humans in a clinical trial launched in 2008 by Dr. Chiorini and his team. After receiving the experimental gene therapy, five of 11 participants with radiation damage experienced an increase in saliva flow. The effects persisted for several years after the one-time treatment, hinting at its potential to bring long-lasting relief. In 2016, Dr. Chiorini’s group launched a second gene therapy trial using a viral delivery vehicle that is less likely to be rejected by the body’s immune system. As of 2023, all 17 trial participants had received the one-time treatment. The researchers expect to publish the initial results in 2024.
“I remember how one patient who never separated from his water bottle realized one day that he wasn’t carrying it anymore,” said Dr. Chiorini, now NIDCR’s Acting Deputy Scientific Director. “It was liberating for him. He went on to run a marathon, something he couldn’t do before because of dry mouth.”
Dr. Chiorini said gene therapy may also benefit people whose salivary water channels have been damaged from Sjögren’s disease, which affects 1 to 4 million people in the United States. Studies using tissue samples from patients and experiments in mice with a Sjögren’s-like condition have shown that the gene therapy can restore saliva output and reduce salivary gland inflammation, pointing to its potential in humans.
Another NIDCR-supported team has developed a nonviral delivery system for therapeutic genes to sidestep the potential for a virus-driven immune reaction. The scientists, led by Michael Passineau, Ph.D., previously at Allegheny Health Network, developed a method that uses ultrasound to puncture tiny holes in cell membranes to deliver water channel-making instructions to radiation-damaged salivary glands. The technique showed promise in animals, and Dr. Passineau has now joined with a University of Michigan team led by Isabelle Lombaert, Ph.D., to obtain FDA approval to launch a trial in humans.
Untangling the root causes of Sjögren’s disease
Patients with Sjögren’s disease experience the same loss of salivary gland function as radiation patients. Scientists and clinicians aren’t entirely clear on what causes the immune system to turn against healthy salivary gland tissue and why symptoms and severity can vary widely among patients.
Hallmarks of Sjögren’s — dry eyes and mouth, fatigue, and joint pain — are also common signs of other health problems, which makes diagnosis difficult. In addition, women are nine times more likely than men to have Sjögren’s, and it often accompanies other immune disorders, such as rheumatoid arthritis or lupus. Scientists suspect the disease may stem from a combination of genetic and environmental factors, including previous infection with a virus or bacteria.
To tease apart the causes of Sjögren’s disease, NIDCR has invested over $29.4 million in large, multisite clinical studies to trace the nature and progression of the disease and to identify the genetic and molecular processes that go awry.
Since 2003, scientists with the Sjögren’s International Collaborative Clinical Alliance (SICCA) have collected and analyzed clinical data and biological specimens from over 3,500 participants around the world. These collections, which are housed in SICCA’s biorepository and data registry, are available to the global scientific community for further study. SICCA scientists, led by Caroline Shiboski, D.D.S., Ph.D., at the University of California, San Francisco, have used the data to develop better diagnostic standards and establish a public library of Sjögren’s-associated genes. Currently, SICCA investigators are exploring gene expression patterns in tissue and cells from Sjögren’s patients in an effort to develop more precise diagnostic methods.
Another large NIDCR-funded clinical study, the Sjögren’s Team for Accelerating Medicines Partnership (STAMP), was launched in 2022 as part of the Accelerating Medicines Partnership® Autoimmune and Immune-Mediated Diseases program led by the National Institute of Arthritis and Musculoskeletal and Skin Diseases. STAMP scientists, also led by Dr. Shiboski, aim to recruit large groups of Sjögren’s patients and healthy participants to better understand the biology of Sjögren’s disease. What they learn may result in better diagnosis, standards of care, and therapies.
“To understand a condition as complex as Sjögren’s, partnerships among patients and diverse teams of scientists are particularly important,” said Preethi Chander, Ph.D., director of the Salivary Biology and Immunology Program in NIDCR’s Division of Extramural Research. “Because the disease occurs mostly in women and can manifest as inflammation in other organs, these cohort studies may also help us understand sex-based differences in other conditions and address chronic inflammation throughout the body.”
Hope on the horizon
Accumulated knowledge on the basic biology of salivary gland function is guiding efforts to regenerate salivary tissue, test experimental therapies, and screen for new drugs.
In recent years, NIDCR investigators have made inroads toward regenerating damaged or diseased salivary glands. Gland regeneration is a notoriously difficult undertaking. It requires growing and maintaining cells in a stem-cell-like state to produce sufficient numbers of mature gland cells. It also requires directing the cells to form the glands’ characteristic 3D branched structures. But a team led by Matthew Hoffman, B.D.S., Ph.D., successfully achieved these two steps by exposing salivary gland stem cells to a protein called neurturin, which is involved in fetal organ development. And researchers led by Ken Yamada, M.D., Ph.D., were able to coax salivary gland cells to undergo “budding,” the embryonic process whereby a flat layer of cells repeatedly folds into bubble-like outgrowths. The budding process eventually culminates in the branched architecture of a mature salivary gland. These findings may serve as a foundation for building artificial salivary glands.
NIDCR Stadtman Tenure Track Investigator Blake Warner, D.D.S., Ph.D., is leading a clinical trial to test the safety and efficacy of an FDA-approved rheumatoid arthritis drug in patients with Sjögren’s. In another NIDCR-supported clinical trial led by Randall Kimple, Ph.D., at the University of Wisconsin-Madison, researchers are testing the feasibility of using a patient’s own cells to repair radiation-damaged salivary glands.
Scientists at the University of Rochester are tackling the problem from another angle by searching for drugs that can prevent radiation damage altogether. They designed a specialized lab dish that holds an array of hundreds of tiny wells, in which human salivary gland cell clusters can be grown and used to rapidly screen for radioprotective drugs. The team, led by Danielle Benoit, Ph.D., plans to test over 800 FDA-approved compounds that could be repurposed for head and neck cancer patients.
“It’s exciting to see researchers embrace emerging technologies and out-of-the-box thinking to tackle salivary gland conditions,” said Dr. Chander. “These studies truly have the potential to change patients’ lives.”
Related Links
References
Alevizos I, Zheng C, Cotrim AP, Liu S, McCullagh L, Billings ME, et al. Late responses to adenoviral-mediated transfer of the aquaporin-1 gene for radiation-induced salivary hypofunction. Gene Ther. 2017 Mar;24(3):176-186. doi: 10.1038/gt.2016.87. Epub 2016 Dec 20.
Lai Z, Yin H, Cabrera-Pérez J, Guimaro MC, Afione S, Michael DG, et al. Aquaporin gene therapy corrects Sjögren's syndrome phenotype in mice. Proc Natl Acad Sci U S A. 2016 May 17;113(20):5694-9. doi: 10.1073/pnas.1601992113. Epub 2016 May 2.
Wang S, Matsumoto K, Lish SR, Cartagena-Rivera AX, Yamada KM. Budding epithelial morphogenesis driven by cell-matrix versus cell-cell adhesion. Cell. 2021 Jul 8;184(14):3702-3716.e30. doi: 10.1016/j.cell.2021.05.015. Epub 2021 Jun 15.
Vining KH, Lombaert IMA, Patel VN, Kibbey SE, Pradhan-Bhatt S, Witt RL, et al. Neurturin-containing laminin matrices support innervated branching epithelium from adult epithelial salispheres. Biomaterials. 2019 Sep;216:119245. doi: 10.1016/j.biomaterials.2019.119245. Epub 2019 Jun 5.
Song Y, Uchida H, Sharipol A, Piraino L, Mereness JA, Ingalls MH, et al. Development of a functional salivary gland tissue chip with potential for high-content drug screening. Commun Biol. 2021 Mar 19;4(1):361. doi: 10.1038/s42003-021-01876-x.
Attention Editors
Reprint this article in your own publication or post to your website. NIDCR News articles are not copyrighted. Please acknowledge NIH's National Institute of Dental and Craniofacial Research as the source.
October 2024